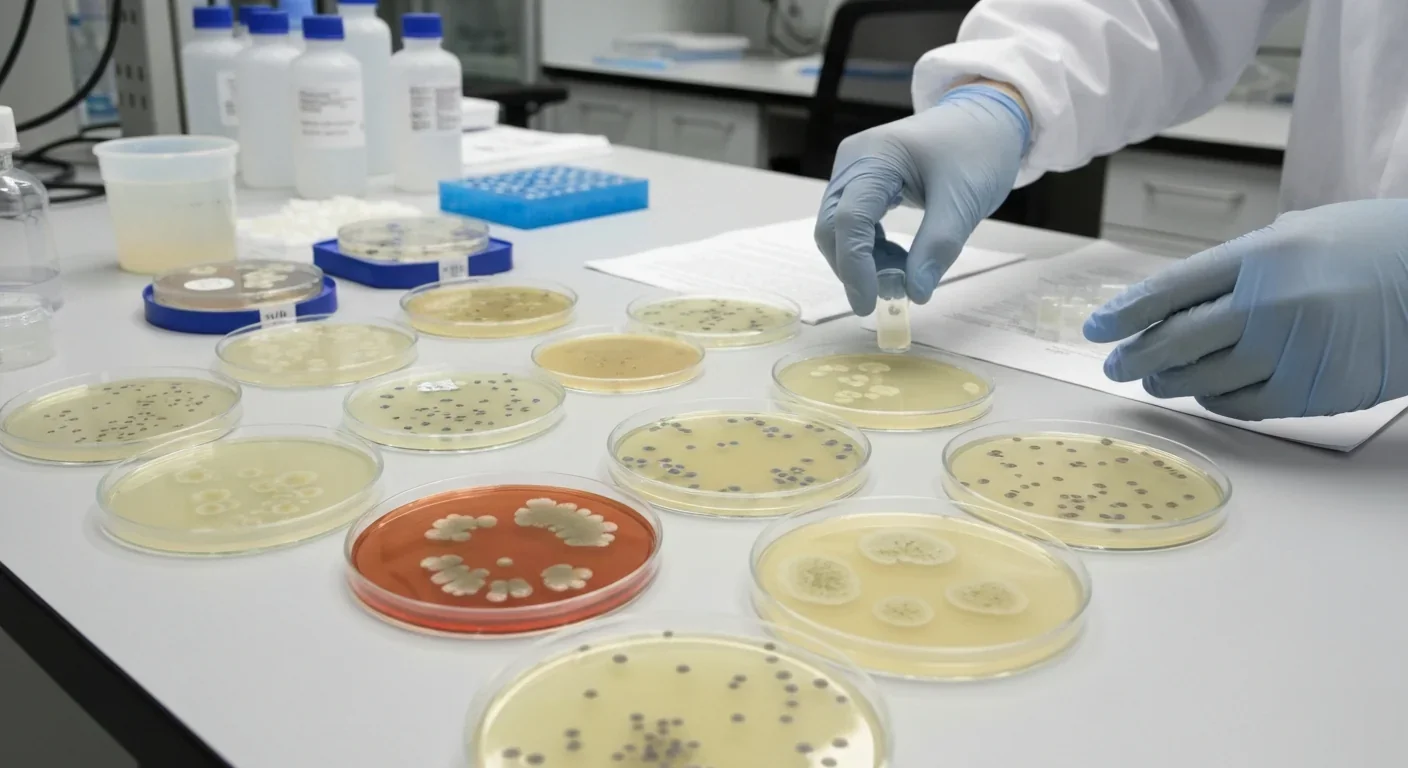
Bacterial biofilm development stages visible in laboratory culture plates

Skunk Cabbage Melts Snow With Its Own Body Heat

TL;DR: Bacteria build sophisticated microscopic cities called biofilms with water channels, specialized workers, and chemical communication networks. These architectural marvels make infections 1,000 times harder to treat but also offer solutions for wastewater treatment and environmental cleanup.
The slime coating your shower curtain is running a city. Not a metaphor - an actual functioning municipality with infrastructure, division of labor, and communication networks that would make urban planners jealous. Scientists studying biofilms have discovered that these bacterial communities build three-dimensional structures so sophisticated they rival human engineering, complete with water distribution systems, specialized workers, and chemical messaging networks that coordinate millions of residents.

This isn't just fascinating biology. Understanding how bacteria architect these microbial metropolises could revolutionize everything from treating chronic infections to designing better wastewater treatment systems. And it's forcing us to reconsider what counts as intelligence in nature.
At the heart of every biofilm lies the extracellular polymeric substance matrix - a self-produced construction material that bacteria extrude to create their living quarters. Think of it as biological concrete, except the builders also manufacture it from scratch using their own metabolic processes.
The EPS matrix combines polysaccharides, proteins, extracellular DNA, and lipids into a structural scaffold that can be rigid as rock or flexible as gelatin, depending on what the community needs. Polysaccharides like alginate and cellulose provide tensile strength, while proteins act as molecular glue holding everything together. Extracellular DNA - genetic material bacteria actively export - creates a sticky mesh that captures nutrients and forms structural cables throughout the matrix.
What makes this remarkable is the precision. Different bacterial species contribute specific components to the matrix, like specialized construction crews each handling different materials. Pseudomonas aeruginosa, for instance, produces alginate polysaccharides that create a protective shell around the community, while other species might specialize in protein adhesins that anchor the biofilm to surfaces.
The EPS matrix isn't static - bacteria continuously remodel it, strengthening some areas while dissolving others as the community's needs change.
The matrix isn't just protective housing. It's a living scaffold that bacteria continuously remodel, strengthening some areas while dissolving others as the community's needs change. Recent microscopy studies reveal the matrix contains gradients of different materials - denser at the base for anchoring, more porous at the surface for nutrient exchange.
Perhaps the most startling discovery about biofilm architecture came in the 1990s when researchers using confocal microscopy first visualized the internal structure of mature biofilms. They found something nobody expected: networks of water channels threading through the bacterial community like blood vessels through tissue.
These aren't random gaps. They're engineered waterways that function as a primitive circulatory system, distributing nutrients from the surrounding environment deep into the biofilm while flushing out metabolic waste products. The channels follow branching patterns remarkably similar to river deltas or human vasculature - structures that evolution has repeatedly discovered as optimal for distribution networks.

Studies of biofilm hydrodynamics show that bacteria actively maintain these channels, preventing them from becoming clogged with debris or overgrown by neighboring cells. When a channel gets damaged, bacteria can reroute flow through alternative pathways, much like traffic rerouting around construction zones.
The channels solve a critical problem for biofilm residents. Bacteria deep inside a thick biofilm would normally suffocate, cut off from oxygen and nutrients. But the water channels deliver fresh supplies to the interior while removing toxic waste products like carbon dioxide and organic acids. It's municipal infrastructure at the microscale.
Not all bacteria in a biofilm are created equal. As communities mature, residents develop distinct identities based on where they live and what job they perform - a phenomenon scientists call metabolic specialization.
Surface dwellers live in an oxygen-rich environment where they can run aerobic metabolism, efficiently harvesting energy from nutrients. These bacteria often serve as the community's power plants, generating energy that diffuses to their neighbors. They also act as the first line of defense, producing antimicrobial compounds that fend off competing microbes trying to colonize the biofilm.
Meanwhile, bacteria in the deep layers experience very different conditions. With little oxygen penetrating the dense matrix, these cells switch to anaerobic metabolism, surviving on fermentation or other oxygen-free energy sources. Some become dormant, entering a slow-metabolic state that makes them incredibly resistant to antibiotics and environmental stress.
"Surface and deep-layer bacteria, though genetically identical, activate completely different gene programs based on their position in the biofilm - like identical twins raised in different environments developing distinct personalities."
- Recent Transcriptomic Studies
Recent transcriptomic studies tracking gene expression in individual biofilm bacteria reveal this specialization runs deep. A surface Pseudomonas cell and a deep-layer Pseudomonas cell, though genetically identical, activate completely different gene programs. It's like identical twins raised in different environments developing distinct personalities.
Some bacteria take on maintenance roles, producing extra EPS matrix material to repair damaged sections. Others specialize in breaking down specific nutrients, sharing the breakdown products with neighbors who can't digest those compounds. This division of labor makes the community far more efficient than any individual bacterium could be.
The specialization creates interdependence. Surface cells might produce oxygen that deep-layer cells need for certain metabolic processes, while deep-layer cells produce compounds that help the surface resist antibiotics. It's mutualism on a microscopic scale - bacteria that would compete as loners cooperating because they're literally in it together.
How do millions of individual bacteria coordinate construction of these elaborate structures? The answer is quorum sensing - a chemical communication system that lets bacteria monitor population density and synchronize their behavior.

Here's how it works. Individual bacteria constantly produce and release signaling molecules called autoinducers. When bacterial populations are sparse, these molecules diffuse away harmlessly. But as population density increases, autoinducer concentrations build up. Once the concentration crosses a threshold - a quorum - it triggers coordinated changes in gene expression across the entire community.
Think of it as a molecular democracy where bacteria literally vote by releasing chemicals. When enough votes accumulate, the population collectively switches behaviors. For biofilm formation, reaching quorum triggers bacteria to start producing EPS matrix components, transition from planktonic swimming to surface attachment, and begin differentiating into specialized roles.
Different species use different autoinducer languages. Pseudomonas aeruginosa uses acyl-homoserine lactones, while Staphylococcus aureus communicates with small peptides. Some bacteria are bilingual, producing multiple autoinducers that regulate different behaviors.
Quorum sensing controls more than just biofilm construction. It governs when to produce toxins, when to become more motile to colonize new territory, when to release enzymes that break down the matrix for dispersal. It's the control system that coordinates the entire biofilm lifecycle.
Scientists have discovered that bacteria also engage in quorum quenching - deliberately degrading competitors' signaling molecules to disrupt their coordination. It's chemical warfare through communication jamming, and it suggests that biofilm formation is often a competitive process where different bacterial species vie for dominance.
Biofilms develop through distinct phases that mirror the growth of human settlements from outposts to cities. Understanding this lifecycle reveals both the sophistication of bacterial engineering and potential intervention points for controlling harmful biofilms.
Phase 1: Initial Attachment. Free-swimming bacteria encounter a surface and make contact. Not every surface works - bacteria are picky colonizers who test surfaces before committing. They use adhesin proteins to sample the surface chemistry and topography. Rough surfaces with nooks and crannies are preferred because they provide protection from fluid flow that might wash the settlers away.
Phase 2: Irreversible Attachment. Once a bacterium decides to settle, it secretes stronger adhesins and begins producing EPS matrix material. This is the point of no return - the cell transitions from a mobile explorer to a permanent resident. Within hours, early colonizers start dividing, forming microcolonies of clonal descendants.
Phase 3: Maturation. This is where the real architecture emerges. As the population expands, bacteria begin constructing the EPS matrix in earnest, forming the three-dimensional structure. Water channels develop, metabolic specialization occurs, and quorum sensing kicks into high gear. The biofilm becomes a true community with emergent properties - capabilities that individual cells don't possess.
Phase 4: Dispersal. Mature biofilms don't last forever. Environmental triggers - nutrient depletion, accumulation of waste products, or signals that better opportunities exist elsewhere - can prompt the community to deliberately dismantle itself. Bacteria release enzymes that break down the EPS matrix, liberating cells to swim away and colonize new territory. It's deliberate urban renewal - abandoning old neighborhoods to build new ones.
The sophisticated structure of biofilms isn't just academically interesting. It's the reason why biofilm-associated infections are up to 1,000 times more resistant to antibiotics than their free-swimming counterparts - a fact that has life-or-death implications for medicine.
The EPS matrix acts as a physical barrier that antibiotics must penetrate. Positively charged antibiotics like aminoglycosides get trapped by negatively charged matrix components, never reaching the bacteria inside. The matrix also contains enzymes that directly inactivate certain antibiotics, creating a protective zone around the community.
But the real problem is metabolic specialization. Antibiotics typically target actively growing bacteria. The slow-growing or dormant bacteria in biofilm deep layers barely notice drugs designed to disrupt cell wall synthesis or protein production. They're like citizens who've gone into hibernation, immune to attacks that only work on active cells.
Bacteria exchange genetic material more readily in biofilms, allowing resistance genes to spread rapidly through communities - turning an entire biofilm antibiotic-resistant within days.
Even more frustrating, bacteria exchange genetic material more readily in biofilms, including genes encoding antibiotic resistance. The close quarters and protective matrix create ideal conditions for horizontal gene transfer - bacteria swapping resistance genes like neighbors sharing tools. A single resistant bacterium can turn an entire biofilm antibiotic-resistant within days.
This matters tremendously for chronic infections. Biofilms on medical implants - catheters, artificial joints, heart valves - are notoriously difficult to eradicate. The bacteria establish communities on the device surface, and no amount of antibiotic treatment can completely clear them. Often, the only solution is removing the implant entirely.
Chronic wound infections, cystic fibrosis lung infections, and recurring urinary tract infections all involve biofilms that repeatedly reseed infections even after antibiotic treatment seems to clear them. The bacteria never really left - they were just hiding in their architectural fortresses.
Biofilm architecture has consequences far beyond medicine. In industrial settings, biofilms cause billions of dollars in damage annually through biofouling - the unwanted colonization of surfaces.
Ship hulls accumulate biofilms that increase drag, reducing fuel efficiency by up to 40%. Water pipes in factories, power plants, and municipal systems get clogged with biofilms that reduce flow, increase pressure requirements, and provide breeding grounds for corrosion-causing bacteria. Heat exchangers lose efficiency as biofilm layers insulate surfaces. Membrane filtration systems become fouled, requiring expensive cleaning or replacement.
The food industry battles biofilms constantly. These communities form on processing equipment and create persistent contamination sources for pathogens like Listeria and Salmonella. Normal cleaning protocols often can't reach bacteria protected by the EPS matrix, leading to recurring contamination events that cost companies millions in recalls.

But biofilm architecture isn't always the enemy. Engineers are learning to harness these structures for beneficial applications. Wastewater treatment plants now deliberately cultivate biofilms on support media in systems called moving-bed biofilm reactors. The bacteria in these engineered biofilms break down organic pollutants, ammonia, and other contaminants far more efficiently than free-floating bacteria.
The architecture matters here too. The water channels in treatment biofilms distribute pollutants throughout the community, ensuring even deep-layer bacteria receive nutrients. The metabolic specialization means different species handle different contaminants - some bacteria break down complex organic molecules into simpler ones, which other species further degrade.
Bioremediation projects use biofilms to clean up contaminated soil and groundwater. The EPS matrix captures pollutants like heavy metals, concentrating them where bacteria can neutralize or transform them into less harmful forms. It's using bacterial architecture as a filtration and processing system.
Recent technological advances are revolutionizing our understanding of biofilm architecture, revealing details that were impossible to see even a decade ago.
Advanced confocal laser scanning microscopy now allows researchers to construct three-dimensional reconstructions of living biofilms without destroying them. By using fluorescent dyes that label specific matrix components or bacterial species, scientists can watch biofilm construction in real time, observing how structures develop and remodel themselves.
Microfluidic devices let researchers grow biofilms under precisely controlled conditions, manipulating nutrient flow, shear forces, and chemical gradients while imaging the results. These "biofilm-on-a-chip" systems reveal how physical forces shape architecture - faster fluid flow creates streamlined, tear-shaped biofilms, while stagnant conditions produce towering mushroom-shaped structures.
"Single-cell transcriptomics can now measure gene expression in individual bacteria while preserving information about where they were located in the biofilm, revealing exactly how position determines cell identity."
- Spatial Biology Research
Perhaps most exciting, single-cell transcriptomics techniques can now measure gene expression in individual bacteria while preserving information about where they were located in the biofilm. This spatial transcriptomics reveals which genes are active in surface versus deep-layer bacteria, showing exactly how position determines cell identity.
Computational modeling is advancing rapidly too. Researchers can simulate biofilm growth using agent-based models where each bacterium is an individual entity following simple rules. The simulations reproduce complex architecture that emerges from interactions between thousands of cells - offering insights into which design principles govern biofilm construction.
Scientists are even studying biofilms in extreme environments to understand the limits of bacterial architecture. Intertidal biofilms survive daily cycles of submersion and desiccation, high UV radiation, and temperature swings - conditions that should destroy cells. Their EPS matrices have evolved special properties that protect residents from these stresses, suggesting design principles for robust engineered biofilms.
Understanding biofilm structure is driving development of therapies that attack the architecture itself rather than trying to kill well-protected bacteria.
Matrix-degrading enzymes are showing promise. DNase enzymes that break down extracellular DNA can destabilize biofilm structure, making bacteria vulnerable to antibiotics or immune system attack. Other enzymes target polysaccharide components, effectively demolishing the EPS construction material.
Quorum sensing inhibitors represent another approach - drugs that block bacterial communication to prevent coordinated biofilm formation or trigger premature dispersal. These don't kill bacteria directly but sabotage their ability to organize, rendering them vulnerable to conventional antibiotics.
Surfactants and chelating agents can disrupt matrix integrity by interfering with electrostatic interactions that hold components together. Some experimental therapies use nanoparticles that penetrate biofilms more effectively than conventional drugs, exploiting the water channels as delivery routes.
Even electrical and ultrasonic treatments are being explored. Weak electrical fields can disrupt biofilms on implanted medical devices, possibly by interfering with electrostatic forces in the matrix. Ultrasound can physically shake biofilms apart, though without destroying the underlying surface.
Attacking the city's infrastructure can be more effective than trying to kill all the residents - demolish the protective architecture, and bacteria become as vulnerable as their planktonic cousins.
The key insight is that attacking the city's infrastructure can be more effective than trying to kill all the residents. Demolish the protective architecture, and the bacteria become as vulnerable as their planktonic cousins.
Biofilm architecture challenges our assumptions about what counts as intelligent design in nature. No individual bacterium possesses a blueprint for a water channel network or understands the community-level structure it's building. Yet through local interactions - responding to chemical signals, producing matrix components, adjusting growth patterns based on immediate neighbors - these communities construct remarkably sophisticated architecture.
It's emergence in action. Complex, coordinated outcomes arising from simple rules followed by individual agents. The phenomenon appears everywhere from ant colonies to stock markets, but bacterial biofilms might be the purest example - single-celled organisms with no nervous system creating infrastructure that solves engineering problems.
This reframes our relationship with microbes. The slimy coating on rocks in a stream isn't just random bacterial slime - it's an engineered structure with water management systems. The plaque on teeth is a multi-species community with specialized residents performing distinct roles. Even the bacterial biofilms in our gut that aid digestion are architectural achievements, communities that establish and maintain themselves through coordinated construction.
Understanding biofilm architecture also offers lessons for human engineering. How do you design self-assembling structures? How do you create systems resilient to damage, with redundant networks that reroute around failures? How do you build using materials produced by the system itself? Bacteria figured this out billions of years ago.
The story of biofilm architecture is still being written. Every new imaging technique, every microfluidic experiment, every transcriptomic study reveals additional sophistication in these bacterial cities. We're learning to read the language of microbial construction - and maybe, in the process, learning how to build better cities of our own.
What's clear is that the line between simple and complex in biology is blurrier than we thought. Give bacteria the right conditions and enough time, and they'll build civilizations invisible to the naked eye but visible to anyone paying attention.

Saturn's moon Titan may harbour liquid water beneath its frozen crust, kept from freezing by ammonia acting as a natural antifreeze. New Cassini data suggests the interior could be slush with warm water pockets rather than a global ocean, and NASA's Dragonfly mission launching in 2028 aims to investigate whether this exotic environment could support life.

The cerebellum, long dismissed as merely a motor coordinator, forms dense circuits with the prefrontal cortex that shape cognition and emotion. Disruption of these pathways is now linked to schizophrenia, autism, and ADHD, opening new frontiers in diagnosis and non-invasive brain stimulation therapies.

Research shows the sharing economy often increases total resource consumption through the Jevons paradox and rebound effects. Ride-sharing adds billions of vehicle miles, co-working spaces use more energy per worker, and diffused responsibility erodes conservation behavior. Breaking the paradox requires congestion pricing, accountability design, and matching sharing models to appropriate resource types.

Illusory superiority causes most people to rate themselves above average in driving, intelligence, and ethics. This bias is rooted in metacognitive blind spots, shaped by culture, and carries real costs in healthcare, finance, and leadership. Structured feedback and institutional safeguards can help, but require ongoing effort.

Eastern skunk cabbage generates its own body heat through the alternative oxidase pathway, maintaining temperatures up to 35°C above freezing air and melting surrounding snow. This thermogenic ability, shared by roughly 90 plant species worldwide, reveals a level of metabolic sophistication that challenges assumptions about plant passivity.

America has 28 vacant homes for every homeless person, yet homelessness hit record highs in 2024. Speculative investment, geographic mismatches, and political barriers explain the paradox, while Finland and Vienna show that Housing First and social housing models can work when the political will exists.

Wafer-on-wafer bonding fuses logic and memory silicon at the atomic level, delivering up to 100x interconnect density over traditional packaging. TSMC, Intel, and Samsung are racing to commercialize the technology as AI chips hit the memory bandwidth wall.